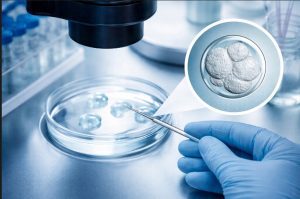
Frozen Embryo Transfer Process by morningsun

Treatments
Clinics/Retreats
Mittal Dental Clinic – Jaipur, Rajasthan
Acharya Dental, Chennai, Tamil Nadu
Dev’s Oral Care, Pune, Maharashtra
Amaya Dental Clinic, Bengaluru, Karnataka
Dental World Super Specialty Clinic, Kolkata, West Bengal
Advamed Hospital & Adbaby IVF Centre, Zirakpur, Punjab

Why Choose Morning Sun?
- ✅ Verified Clinics Only – We list only reputed, trusted, and accredited healthcare providers.
- 🌍 Medical Tourism Friendly – Tailored for international patients seeking world-class care in India.
- 🏆 Luxury + Wellness – Combining modern treatments with premium Ayurveda and wellness experiences.
- 📚 Expert Knowledge Hub – Articles, cost guides, and insights reviewed by medical & Ayurveda advisors.
Top Treatments We Cover
🌿 Ayurveda & Wellness Retreats – Authentic healing experiences in luxury resorts across India.
🧬 IVF & Fertility Clinics – Advanced reproductive care in India’s best centers.
💎 Cosmetic & Dermatology – Hair transplant, cosmetic surgery, anti-aging, and skin care.
🦷 Dental Tourism – High-quality dental implants, cosmetic dentistry, and smile makeovers.


How It Works
1️⃣ Discover Clinics – Search by treatment and city.
2️⃣ Compare Options – Verified listings with transparent details.
3️⃣ Enquire Securely – Minimum data required, direct connection to clinics.
4️⃣ Start Your Journey – Receive trusted guidance from partners.
Patient Trust & Global Reach
🌍 Trusted by patients from 50+ countries
🤝 Partnerships with India’s top IVF, cosmetic, dental, and Ayurveda centers
⭐ Advisory board of medical and wellness experts
🌐 Comprehensive care combining advanced medicine with holistic wellness

Build confidence before you choose your clinic
📰 Explore our Knowledge Hub – cost guides, treatment FAQs, patient success stories, and Ayurveda insights.
- Importance of Hydration for Health
- IVF Failure: Understanding the Reasons and What Comes Next
- Frozen Embryo Transfer: Process and Benefits
- Breathing Exercises for Anxiety and Stress
- Why India Is a Global Hub for Dental Tourism
- Best Skincare Routine for Oily Skin in Humid Climate
✨ Start your journey with Morning Sun today.
Discover trusted clinics, connect securely, and experience India’s best healthcare & wellness.
Morning Sun
MorningSun.in is India’s premium health, wellness, and medical tourism portal. From IVF and cosmetic surgery to dental tourism and Ayurveda retreats, we help patients find trusted clinics and luxury wellness centers. With expert-backed content, verified listings, and international patient support, we make medical tourism in India simple, secure, and stress-free.